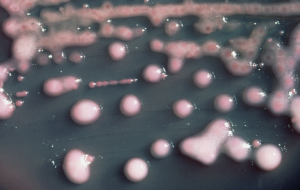

Si è appena conclusa in Commissione Lavoro del Senato l’audizione ...
Yearly Archives : 2016
Picchia, rapina e minaccia un uomo adescato su Badoo: 24enne ai domiciliari
I carabinieri del nucleo operativo e radiomobile della compagnia di ...
I quotidiani a scuola: ad Ostuni i giornalisti contribuiscono alla didattica
“I quotidiani a scuola: il contributo dei giornalisti alla didattica”: ...
Aggredisce studente con coltellino: anziano denunciato per lesioni personali
I carabinieri della locale stazione, unitamente a personale del nucleo ...
New Volley Dolphin San Vito: stagione trionfale per le giovanili
Bilancio positivo nella prima parte di stagione per la NEW ...
25enne con problemi psichici spara alla polizia con carabina ad aria compressa, poi fugge con un coltello: catturato
Momenti di tensione nella mattinata di oggi in via Vienna ...
Blitz dei poliziotti della Città Bianca: fermato con 5 Kg di hashish
Avrebbe rifornito la piazza dello spaccio con un’ingente quantitativo di ...
Nuovo Teatro Verdi: “Non ti pago” rinviato al 26 maggio
Lo spettacolo «Non ti pago», inserito nel cartellone della stagione ...
Francavilla, Curto: “Bruno all’angolo, ha una sola via d’uscita: faccia una giunta monocolore”
“Il Consiglio comunale di ieri ha fatto emergere una ...
CSV: il presidente Spedicato traccia un bilancio a quattro mesi dalla scadenza del mandato
Il prossimo 27 maggio si terrà a Brindisi l’Assemblea Elettiva ...
Provincia: convocati consiglio comunale ed assemblea dei Sindaci
Il Presidente della Provincia, Maurizio Bruno, ha convocato per giovedì ...
Il turismo può essere volano della nostra economia (Forum Ambiente, Salute e Sviluppo)
La decisione del Governo di sottomettere la gestione del porto ...
La Giornata della Memoria all’I.C. Santa Chiara
Mercoledì 27 gennaio: una giornata interamente dedicata alla Memoria nell’Istituto ...
Cedas Avio: grande partecipazione al raduno con gli osservatori del Bari
Grande successo per il raduno selettivo organizzato lunedí pomeriggio dalla ...
INPhoto: venerdì seminario su “Identità e funzioni del reportage sociale”
Per il “ Centro formazione per la fotografia autoriale” , ...
Ass. Argentieri: completato l’iter per i contributi libri di testo
A conclusione dei procedimenti relativi ai contributi sui libri di ...
A Cisternino si presenta il libro “ Eutopia” di Francesco Colizzi
In occasione della 63ª giornata mondiale dei malati di lebbra ...
Confesercenti: Lubes e Casale nuovi responsabili territoriali di Ostuni
La Confesercenti provinciale di Brindisi, allo scopo di rendere più ...
Ad Ostuni torna la “Passione”
Dopo l’enorme successo della prima edizione il 20 e il ...
Nucleo 2000: oggi conferenza su “Aristotele ed Epicuro”
Il Circolo culturale Nucleo 2000 di Brindisi, presieduto da Lyda ...
Karate: Samuel Stea convocato in Nazionale
Dopo uno strepitoso 2015 e dopo le considerevoli prestazioni dell’atleta ...
Xylella, Mariano: “ripartire dal piano del Ministro Martina”
“Contro l’emergenza xylella ripartiamo dal Piano del Governo illustrato ieri ...
Quattro sindacati contro il dirigente: c’è maretta nei vigili del Fuoco, chiesto l’intervento del Prefetto
Si è tenuta nella mattinata del 25 gennaio u.s. presso ...
Il Lupo e l’Agnello
La continua e pressante opera di demolizione che gli uomini ...
Cine qua non: gli appuntamenti della settimana
Continuano gli appuntamenti del ricco programma proposto dal “Cine Qua ...
Sanità, Romano: “La Puglia regione di serie B? Il confronto con l’Emilia: 800 mln di euro e 20mila dipendenti in meno”
Il Consigliere regionale del PD, Pino Romano Presidente della III ...
Ma quanto ci vuole ad aggiustare le lampade del lungomare? Di Raffaele Giove
Ci vogliono anni nella nostra città per la sostituzione delle ...
Frammenti di una ballata: ad Ostuni torna il commovente spettacolo sulla Shoah
Per ricordare l’Olocausto agli studenti, torna nella settimana in cui ...
Il Mare d’inverno: Fare Verde pulisce gli arenili di Camerini, Punta Penna Grossa ed Ex Lido Poste
Fare Verde sarà a pesca … di rifiuti, con l’iniziativa ...
Dipietrangelo: “una città tra burattinai e incubi”
Leggo che sono chiamato in causa sulle vicende politiche e ...
Donato defibrillatore al terzo istituto comprensivo di Francavilla Fontana
I piccoli studenti del terzo istituto comprensivo di Francavilla Fontana ...
Giornata della Memoria: a San Vito seduta aperta del Consiglio Comunale dei Ragazzi
L’Amministrazione Comunale di San Vito dei Normanni, Assessorato alla Pubblica ...
A Francavilla si presenta libro su Sandro Pertini
Sabato 30 gennaio presso il Cinema Teatro Italia di Francavilla ...
Ciracì (CoR): “Caroli esclude Ceglie dalla convezione per promuovere le testimonianze archeologiche messapiche”
“È assurdo che l’unico Comune a mancare nella convenzione ...
Cisl: “finalmente la stabilizzazione per i lavoratori dell’Asl”
Si vede la luce alla fine del tunnel!!! Così per ...
Unioni Civili e Stepchild Adoption , Sen. Iurlaro (Ala): “Voto sì e vi spiego perché”
Unioni civili e “adozioni”: credo sia utile alimentare un dibattito, ...
Cedas Avio: allievi Ok, giovanissimi Ko
Ancora un successo per la formazione Allievi della Cedas Avio ...
Antonio Greco (Gruppo Folk “Città di Ostuni”) riceve il premio “Padri del Folklore”
È stato consegnato ad Antonio Greco, Presidente del Gruppo ...
Nascondevano droga nei vestiti dei bambini: i nomi, le foto, il video e i dettagli dell’operazione
13 persone sono state tratte in arresto all’alba di oggi ...
In biblioteca regaliamo cultura: domani il primo appuntamento
La Provincia di Brindisi, la Biblioteca provinciale e la Bottega ...
La Provincia di Brindisi cerca contributi per il piano anticorruzione
Nell’ambito delle iniziative e delle attività condotte in materia di ...
Educazione ambientale: un tavolo di lavoro all’I.C. Sant’Elia-Commenda
In data 28 gennaio 2016, alle ore 17.00, presso l’Aula ...
La Junior Fasano sempre più forte: tesserato il centrale brasiliano Andre Leal
La Junior Fasano comunica che in queste ore sta perfezionando ...
Terzo tempo web: il video di Bologna-Brindisi
In difficoltà per gran parte del match, l’Enel rientra in ...
Giornata della Memoria: a Francavilla “Il silenzio di Abram mio padre dopo Auschwitz”
L’Associazione artistico culturale musicale “ArmoniE” di Francavilla Fontana (BR), nella ...
Droga nei vestiti dei bambini per sfuggire ai controlli: 14 arresti nel brindisino
Per eludere i controlli delle forze dell’ordine nascondevano la droga ...
L’Arch. Gervasi sulla riqualificazione di Largo Gelso, Piazza Sant’Antonio e dello stabile adiacente al Tito Schipa
Riceviamo e pubblichiamo integralmente un interventi dell’arch. Emanuela Gervasi – ...
Sabato a Carovigno si presenta “Dalla punta dei piedi alle ciglia” di Marco Saponaro
Sabato 30 Gennaio ore 19:00 presso il castello Dentice di ...
Giornata della Memoria: mercoledì 27 due iniziative al Teatro Comunale di Ceglie M.ca
L’Amministrazione Comunale di Ceglie Messapica (Assessorato alla Cultura – “Progetti per ...
La Protezione Civile di Brindisi sbarca su “Telegram Messenger”
La protezione civile del comune di Brindisi sbarca su “Telegram ...
Riunione interlocutoria a Bari per il passaggio dei lavoratori da Nubile ad Amiu
Si è svolto oggi presso la task force della Regione ...
Klebisella, Asl: “seguiamo tutti i protocolli ministeriali per evitare contaminazioni”
Nell’autunno scorso questa Azienda ha nominato un Gruppo di Lavoro ...
Autorità portuali domani alla Stato-Regioni, Bozzetti: “Emiliano porterà la sua posizione non quella dei pugliesi”
Si terrà domani in sede di conferenza Stato-Regioni l’incontro con ...
Ostuni espugna Ruvo e si prepara per due gare importantissime
Talos Ruvo – Cestistica Ostuni 75-82 (14-27; 35-47; 43-67) RUVO: ...
Carnevale Mesagnese: tutto pronto per il primo appuntamento di domenica prossima
Tutto pronto anche a Mesagne per il consueto appuntamento con ...
Vertenza Dema, la società: “la crisi dipende da Agusta Westland ma abbiamo portato a Brindisi altre commesse”
Alla luce delle ultime informazioni circolate e non veritiere, in ...
Asl: potenziato l’organico medico del Pronto Soccorso
Parallelamente agli interventi strutturali ed organizzativi messi in campo per ...
Handiamo: STP e Coop. Eridano insieme per l’integrazione delle persone con disabilità
Martedi 26 gennaio ore 17:00 PuntoSTP – Ufficio per le ...
Consales dopo il fallimento della raccolta firme: “strane alleanze ma anche oggi qualcuno ha detto no ad un circo con animali”
Dopo il fallimento del tentativo di far decadere la sua ...
Teatri a vapori: giovedì in anteprima “Pop Corn” al Binario 23
Il prossimo 28 gennaio, al Binario23, prosegue la rassegna TEATRI ...